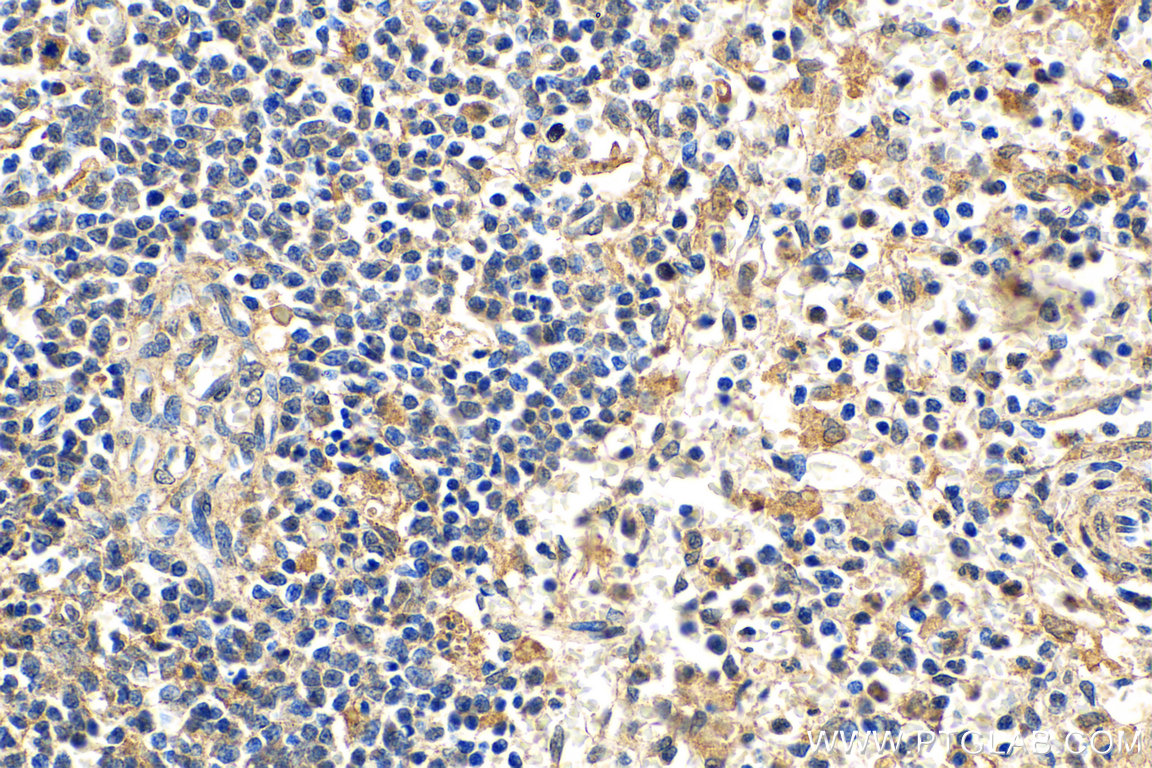
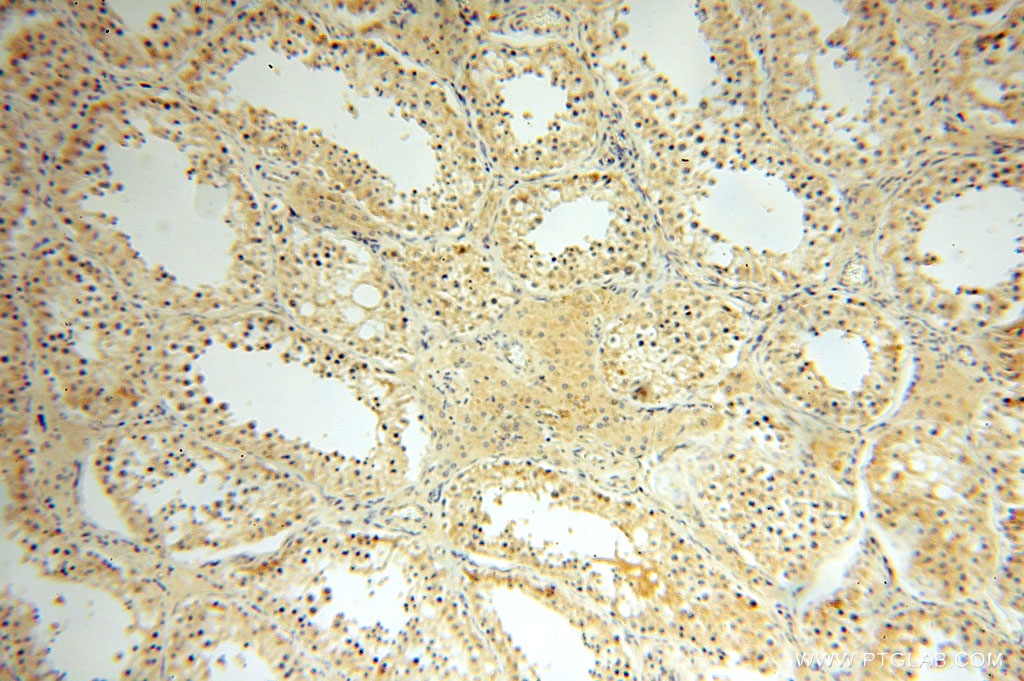

验证数据展示
经过测试的应用
| Positive WB detected in | HeLa cells, K-562 cells, Ramos cells |
| Positive IHC detected in | human liver cancer tissue, human spleen tissue, human kidney tissue, human heart tissue, human testis tissue, human skin tissue, human brain tissue Note: suggested antigen retrieval with TE buffer pH 9.0; (*) Alternatively, antigen retrieval may be performed with citrate buffer pH 6.0 |
推荐稀释比
| 应用 | 推荐稀释比 |
|---|---|
| Western Blot (WB) | WB : 1:500-1:3000 |
| Immunohistochemistry (IHC) | IHC : 1:50-1:500 |
| It is recommended that this reagent should be titrated in each testing system to obtain optimal results. | |
| Sample-dependent, Check data in validation data gallery. | |
产品信息
16744-1-AP targets IL-15RA in WB, IHC, IF, ELISA applications and shows reactivity with human samples.
| 经测试应用 | WB, IHC, ELISA Application Description |
| 文献引用应用 | WB, IHC, IF |
| 经测试反应性 | human |
| 文献引用反应性 | human, hamster |
| 免疫原 |
CatNo: Ag10151 Product name: Recombinant human IL-15RA protein Source: e coli.-derived, PGEX-4T Tag: GST Domain: 1-231 aa of BC107777 Sequence: MSVEHADIWVKSYSLYSRERYICNSGFKRKAGTSSLTECVLNKATNVAHWTTPSLKCIRDPALVHQRPAPPSTVTTAGVTPQPESLSPSGKEPAASSPSSNNTAATTAAIVPGSQLMPSKSPSTGTTEISSHESSHGTPSQTTAKTWELTASASHQPPGVYPQGHSDTTVAISTSTVLLCGLSAVSLLACYLKSRQTPPLASVEMEAMEALPVTWGTSSRDEDLENCSHHL 种属同源性预测 |
| 宿主/亚型 | Rabbit / IgG |
| 抗体类别 | Polyclonal |
| 产品类型 | Antibody |
| 全称 | interleukin 15 receptor, alpha |
| 别名 | IL15RA, CD215, IL 15 receptor subunit alpha, IL 15R alpha, IL 15RA |
| 计算分子量 | 231 aa, 24 kDa |
| 观测分子量 | 50 kDa |
| GenBank蛋白编号 | BC107777 |
| 基因名称 | IL-15RA |
| Gene ID (NCBI) | 3601 |
| RRID | AB_2233644 |
| 偶联类型 | Unconjugated |
| 形式 | Liquid |
| 纯化方式 | Antigen affinity purification |
| UNIPROT ID | Q13261 |
| 储存缓冲液 | PBS with 0.02% sodium azide and 50% glycerol, pH 7.3. |
| 储存条件 | Store at -20°C. Stable for one year after shipment. Aliquoting is unnecessary for -20oC storage. |
背景介绍
Interleukin-15 (IL-15) is a pleiotropic cytokine that plays an important role in both innate and adaptive immunity. IL-15 is mainly produced by activated monocytes, macrophages and dendritic cells, and is structurally similar to IL-2 (PMID: 8178155; 12401478). These two cytokines share the same IL-2/15Rβ and common γ-chain receptor subunits. In addition, IL-2 and IL-15 have their own private α-chain receptor subunit, IL-2Rα and IL-15Rα, respectively (PMID: 7641685). The IL-15Rα chain is expressed by many cell types including monocytes, DCs, NK, T cells and fibroblasts. Several isoforms of IL-15Rα exist and are generated either by alternative splicing or by proteolytic cleavage (PMID: 10480910; 15265897). The calculated molecular weight of full-length IL-15Rα is 28 kDa, IL-15Rα can be glycosylated, and larger apparent molecular weights have been reported (PMID: 10480910; 15976182; 15671076; 17912462).
实验方案
| Product Specific Protocols | |
|---|---|
| IHC protocol for IL-15RA antibody 16744-1-AP | Download protocol |
| WB protocol for IL-15RA antibody 16744-1-AP | Download protocol |
| Standard Protocols | |
|---|---|
| Click here to view our Standard Protocols |
发表文章
| Species | Application | Title |
|---|---|---|
Nat Commun An Artificial Intelligence-guided signature reveals the shared host immune response in MIS-C and Kawasaki disease. | ||
Clin Sci (Lond) HMGB1-induced autophagy facilitates hepatic stellate cells activation: a new pathway in liver fibrosis. | ||
Stem Cells Dev Human gastric cancer mesenchymal stem cell-derived IL15 contributes to tumor cell EMT via up-regulation of Tregs ratio and PD-1 expression in CD4+T cell. | ||
Immunology Interleukin-15 receptor α expression in inflammatory bowel disease patients before and after normalization of inflammation with infliximab. | ||